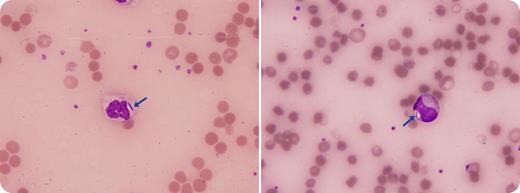
A 66-year-old diabetic man presented with breathlessness, vomiting, and fever. His initial blood count demonstrated hemoglobin 135 g/L (130-175), platelets 155 × 109/L (150-400), and white blood cells 18.3 × 109/L (4-11). His hemoglobin fell rapidly over 6 hours to 44 g/L, platelets fell to 39 × 109/L, and white blood cells increased to 20.4 × 109/L. d-Dimer assay was 35 857 ng/mL (<250), fibrinogen was 0.3 g/L (1.5-4), and international normalized ratio was 3.6, supporting a diagnosis of disseminated intravascular coagulopathy. The blood serum turned black secondary to hemolysis. The peripheral blood film showed microspherocytes with erythrophagocytosis and thrombocytopaenia. Neutrophils showed left shift and vacuolation. Two band forms were identified with an intracytoplasmic bacillus. Despite intensive care support and intravenous antibiotics, the patient arrested and was pronounced dead 6 hours following admission. Subsequently, blood samples cultured a Clostridium perfringens isolate. / C. perfringens commonly secretes an α toxin that has phospholipase activity. This can induce massive hemolysis by disrupting cell membrane integrity through the hydrolysis of sphingomyelin and lecithin. Massive intravascular hemolysis is a rare but well-documented complication and is often rapidly fatal. Risk factors include diabetes and underlying hematologic disorders.

A 66-year-old diabetic man presented with breathlessness, vomiting, and fever. His initial blood count demonstrated hemoglobin 135 g/L (130-175), platelets 155 × 109/L (150-400), and white blood cells 18.3 × 109/L (4-11). His hemoglobin fell rapidly over 6 hours to 44 g/L, platelets fell to 39 × 109/L, and white blood cells increased to 20.4 × 109/L. d-Dimer assay was 35 857 ng/mL (<250), fibrinogen was 0.3 g/L (1.5-4), and international normalized ratio was 3.6, supporting a diagnosis of disseminated intravascular coagulopathy. The blood serum turned black secondary to hemolysis. The peripheral blood film showed microspherocytes with erythrophagocytosis and thrombocytopaenia. Neutrophils showed left shift and vacuolation. Two band forms were identified with an intracytoplasmic bacillus. Despite intensive care support and intravenous antibiotics, the patient arrested and was pronounced dead 6 hours following admission. Subsequently, blood samples cultured a Clostridium perfringens isolate.
C. perfringens commonly secretes an α toxin that has phospholipase activity. This can induce massive hemolysis by disrupting cell membrane integrity through the hydrolysis of sphingomyelin and lecithin. Massive intravascular hemolysis is a rare but well-documented complication and is often rapidly fatal. Risk factors include diabetes and underlying hematologic disorders.
A 66-year-old diabetic man presented with breathlessness, vomiting, and fever. His initial blood count demonstrated hemoglobin 135 g/L (130-175), platelets 155 × 109/L (150-400), and white blood cells 18.3 × 109/L (4-11). His hemoglobin fell rapidly over 6 hours to 44 g/L, platelets fell to 39 × 109/L, and white blood cells increased to 20.4 × 109/L. d-Dimer assay was 35 857 ng/mL (<250), fibrinogen was 0.3 g/L (1.5-4), and international normalized ratio was 3.6, supporting a diagnosis of disseminated intravascular coagulopathy. The blood serum turned black secondary to hemolysis. The peripheral blood film showed microspherocytes with erythrophagocytosis and thrombocytopaenia. Neutrophils showed left shift and vacuolation. Two band forms were identified with an intracytoplasmic bacillus. Despite intensive care support and intravenous antibiotics, the patient arrested and was pronounced dead 6 hours following admission. Subsequently, blood samples cultured a Clostridium perfringens isolate.
C. perfringens commonly secretes an α toxin that has phospholipase activity. This can induce massive hemolysis by disrupting cell membrane integrity through the hydrolysis of sphingomyelin and lecithin. Massive intravascular hemolysis is a rare but well-documented complication and is often rapidly fatal. Risk factors include diabetes and underlying hematologic disorders.
For additional images, visit the ASH IMAGE BANK, a reference and teaching tool that is continually updated with new atlas and case study images. For more information visit http://imagebank.hematology.org.